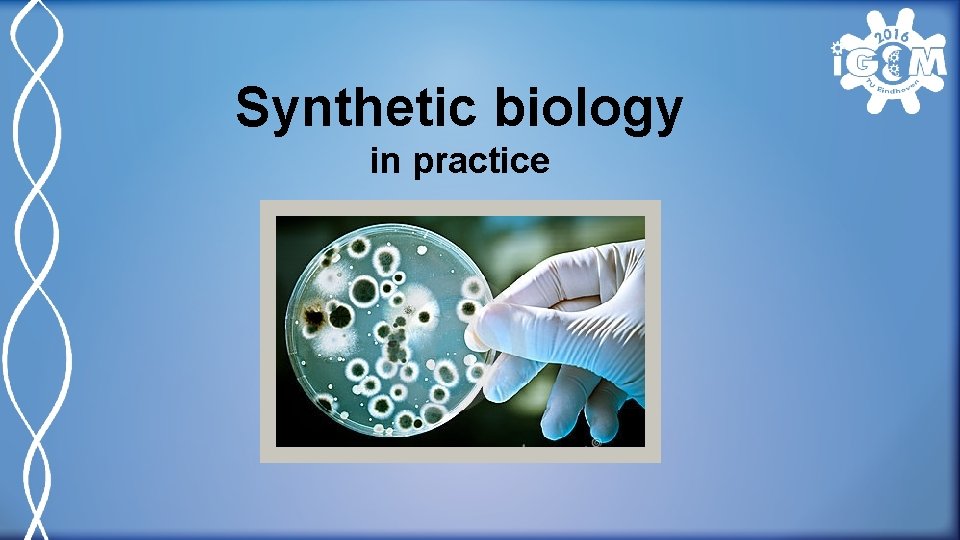
Synthetic biology in practice
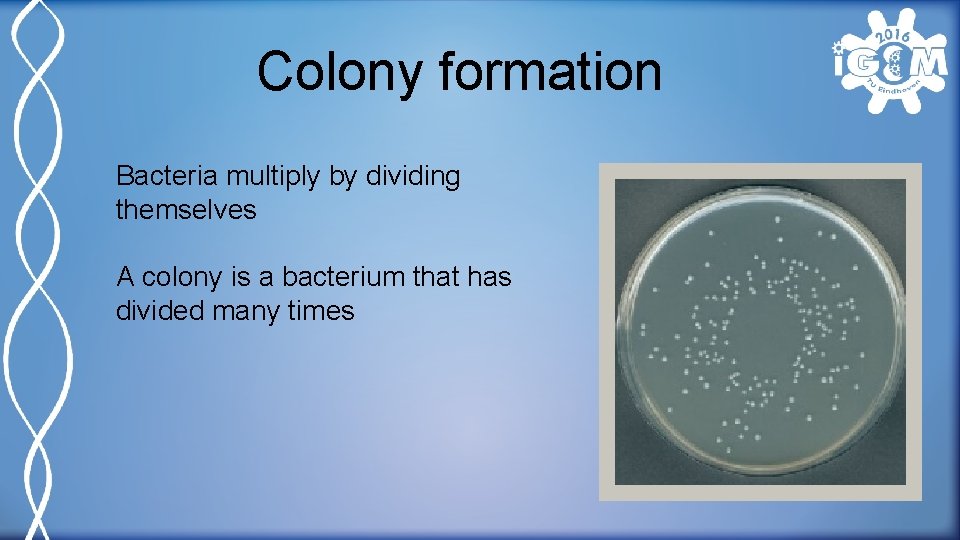
Colony formation Bacteria multiply by dividing themselves A colony is a bacterium that has

Synthetic biology in practice What is synthetic biology
Synthetic biology in practice

What is synthetic biology? The adaption of cells or bacteria, so the can compute certain tasks.

Cells • Nucleus • ER • Organelles Regulated by protein reactions

DNA Deoxyribonucleic acid Contains heredity information 4 bases: A, T, G and C Building plan for proteins

From DNA to protein

Bacteria 1 cell organisms Linear DNA Plasmids - exchangeable - antibiotic resistance Often used by humans

Production of proteins By use of bacteria Plan of action: • Make a plasmid with the gene inside • Bring plasmid into bacteria • Check the plasmid • Production of proteins

Digestion Cutting of the gene and plasmid Two restriction enzymes For example: • Hind. III • Bam. HI

Digestion exercises Part Needed mass/concentration DNA of gene (200 ng/ μL) 10 x Cut. Smart buffer Restriction enzyme 3 μg 1 x 10 U 15 μL 5 μL 0. 5 μL Bam. HI (20 U/ μL) Restriction enzyme 10 U 0. 5 μL Hind. III (20 U/ μL) H 20 Total 20 bases long final volume 29 μL 50 μL

Ligation Putting the open plasmid and gene together Gives a closed plasmid with the gene inside

Ligation exercises Why is the digestion executed with two different, and not with one restriction enzyme? When only one restriction enzyme is used, the plasmid can close again without the gene inside.

Plan of action: • Make a plasmid with the gene inside • Bring plasmid into bacteria • Check the plasmid • Production of proteins

Transformation Give bacteria a heat shock Spread cells onto a plate Cells will divide overnight

Transformation excercises What is the function of the heat shock? The heat shock opens the cell wall of the bacteria, so the plasmid can go trough. Why is it important that the matrix of the plate contains (the correct) antibiotic? Otherwise all kinds of bacteria, also the ones were the transformation has not been successful, can multiply on the plate. What do you expect that would happen during the transformation if the ligation has not been successful? These bacteria do not contain the right antibiotic resistence. The bacteria will not grow on the plate.
Colony formation Bacteria multiply by dividing themselves A colony is a bacterium that has divided many times

Colony formation exercises How is a colony formed? When 1 bacterium divides itself many times, the bacteria become visible for the human eye. We call this a colony. Why is it very handy for research that bacteria form colonies? A colony is many times the same bacterium, because of this we know we go on with the same plasmid. Why are the plates saved in the refrigerator? At 4 degrees the bacetria will no longer divide.

Culturing Making a culture of a few colonies A culture contains: • LB medium (nutrients) • Antibiotic • Bacterium colony The tubes will be hold on 37 degrees and shaken the whole night

Culturing exercises • A bacterium divides every 20 minutes • You start with 50 bacteria • You want 5 million bacteria How long do you need to wait? N= B*G^t 50*2^t= 5. 000 2^t= 100. 000 t= ln(100. 000)/ln(2)= 16. 6*20 minutes= 332 minutes= 5 hours and 32 minutes Why is it necessary that the tubes are shaken? When the tubes are shaken, the bacteria and the nutrients spread evenly through the tube. More importantly the bacteria will get enough oxygen this way.

Plan of action: • Make a plasmid with the gene inside • Bring plasmid into bacteria • Check the plasmid • Production of proteins

Plasmide zuivering => DNA sequensen Houden alleen de plasmiden over Controleren of gen daadwerkelijk in de plasmide zit Opsturen voor sequensen Dit wordt door gespecialiseerde bedrijven gedaan

DNA sequencing Sanger method Every tube contains 4 normal bases Every tube contains 1 colored base The DNA will not be extended when a colored base is build in.

DNA sequencing exercises What is the base pair sequence? CGCGATTACGTC

Plan of action: • Make a plasmid with the gene inside • Bring plasmid into bacteria • Check the plasmid • Production of proteins

Protein production DNA is read by polymerase Proteins are formed

Protein purification Only the purified protein is left over Testing of the protein Describe the results

Plan of action: • Make a plasmid with the gene inside • Bring plasmid into bacteria • Check the plasmid • Production of proteins

Interested? i. GEM is a yearly worldwide competition in synthetic biology. Hundreds of teams work on there own project. All teams come together in Boston to show there results More information: www. igem. org http: //2016. igem. org/Team: TU-Eindhoven
- Slides: 27